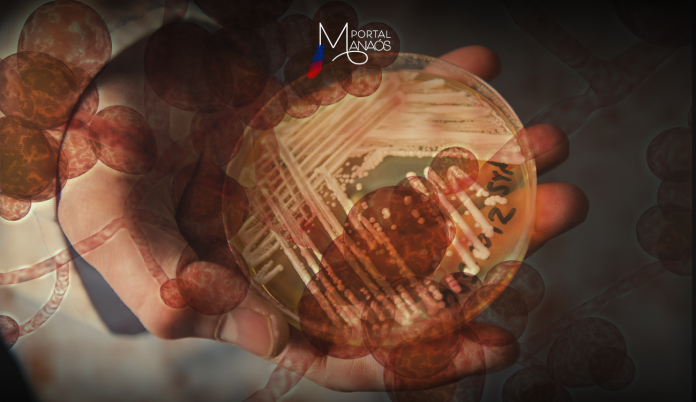
capa 6 (1)

O fungo Candida Auris é resistente à medicamentos e responsável por infecções hospitalares.
Segundo a Anvisa, em documento de 11 de janeiro de 2022, foram identificados no primeiro mês deste ano dois casos de infecção pelo fungo envolvendo um paciente de 67 anos e outra de 70 anos que estavam internados num hospital da rede pública do Recife.
Durante esses anos de pandemia, a Anvisa identificou 18 casos da infecção em três surtos diferentes. O primeiro caso confirmado foi identificado em uma amostra da ponta de um cateter de paciente internado em UTI de Salvador, local dos dois primeiros surtos: um em dezembro de 2020 (com 15 casos e dois mortos em um hospital da rede privada) e outro em dezembro de 2021 (com um caso em um hospital da rede pública).
De acordo com a Anvisa, “pode-se considerar que há um surto de Candida auris porque a definição epidemiológica de surto abrange não apenas uma grande quantidade de casos de doenças contagiosas ou de ordem sanitária, mas também o surgimento de um microrganismo novo na epidemiologia de um país ou até de um serviço de saúde – mesmo se for apenas um caso. ”
- Fonte: Informações da redação com G1
- Foto: Divulgação.